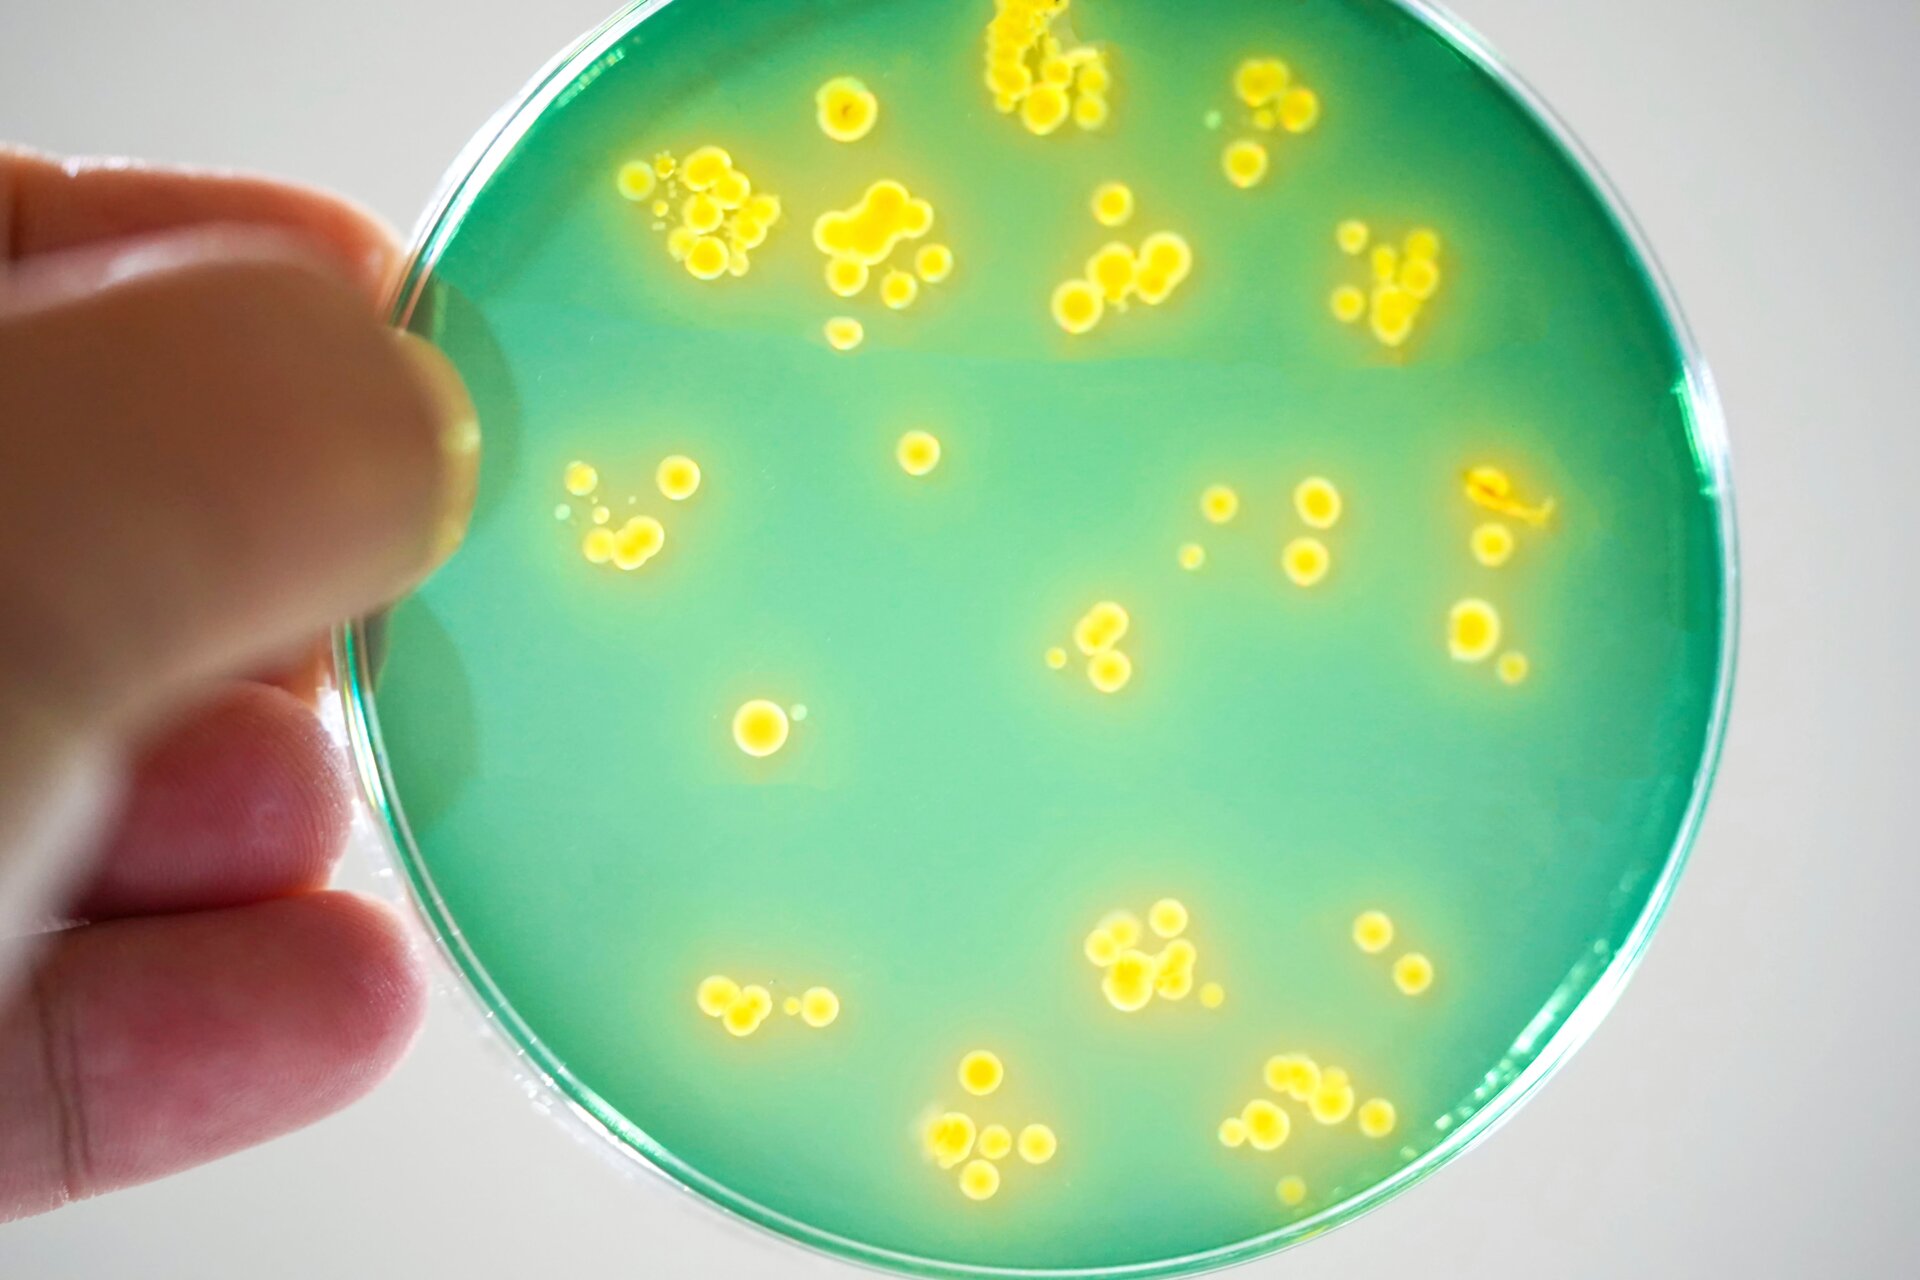
Las bacterias vibrio se cultivan en una placa de petri.

vibrio
La causa reportada de la infección del pie retorcido de Brent Norman, en realidad, hay muchos tipos diferentes de vibrio bacterias que viven en el agua de mar, solo algunos de los que pueden enfermar a los humanos. V. cholerae es el homónimo y la causa del cólera, mientras que V. vulnificus Se sabe que rara vez causa infecciones carnívoras cuando las bacterias se introducen en el cuerpo a través de una herida abierta. La etiqueta es una nombre inapropiado, ya que las bacterias en realidad no nos están comiendo vivos, pero estas infecciones ciertamente pueden ser fatales o causar amputación si no se detectan y tratado con suficiente antelación.
Este contenido ha sido traducido automáticamente del material original. Debido a los matices de la traducción automática, pueden existir ligeras diferencias.Para la versión original, haga clic aquí.